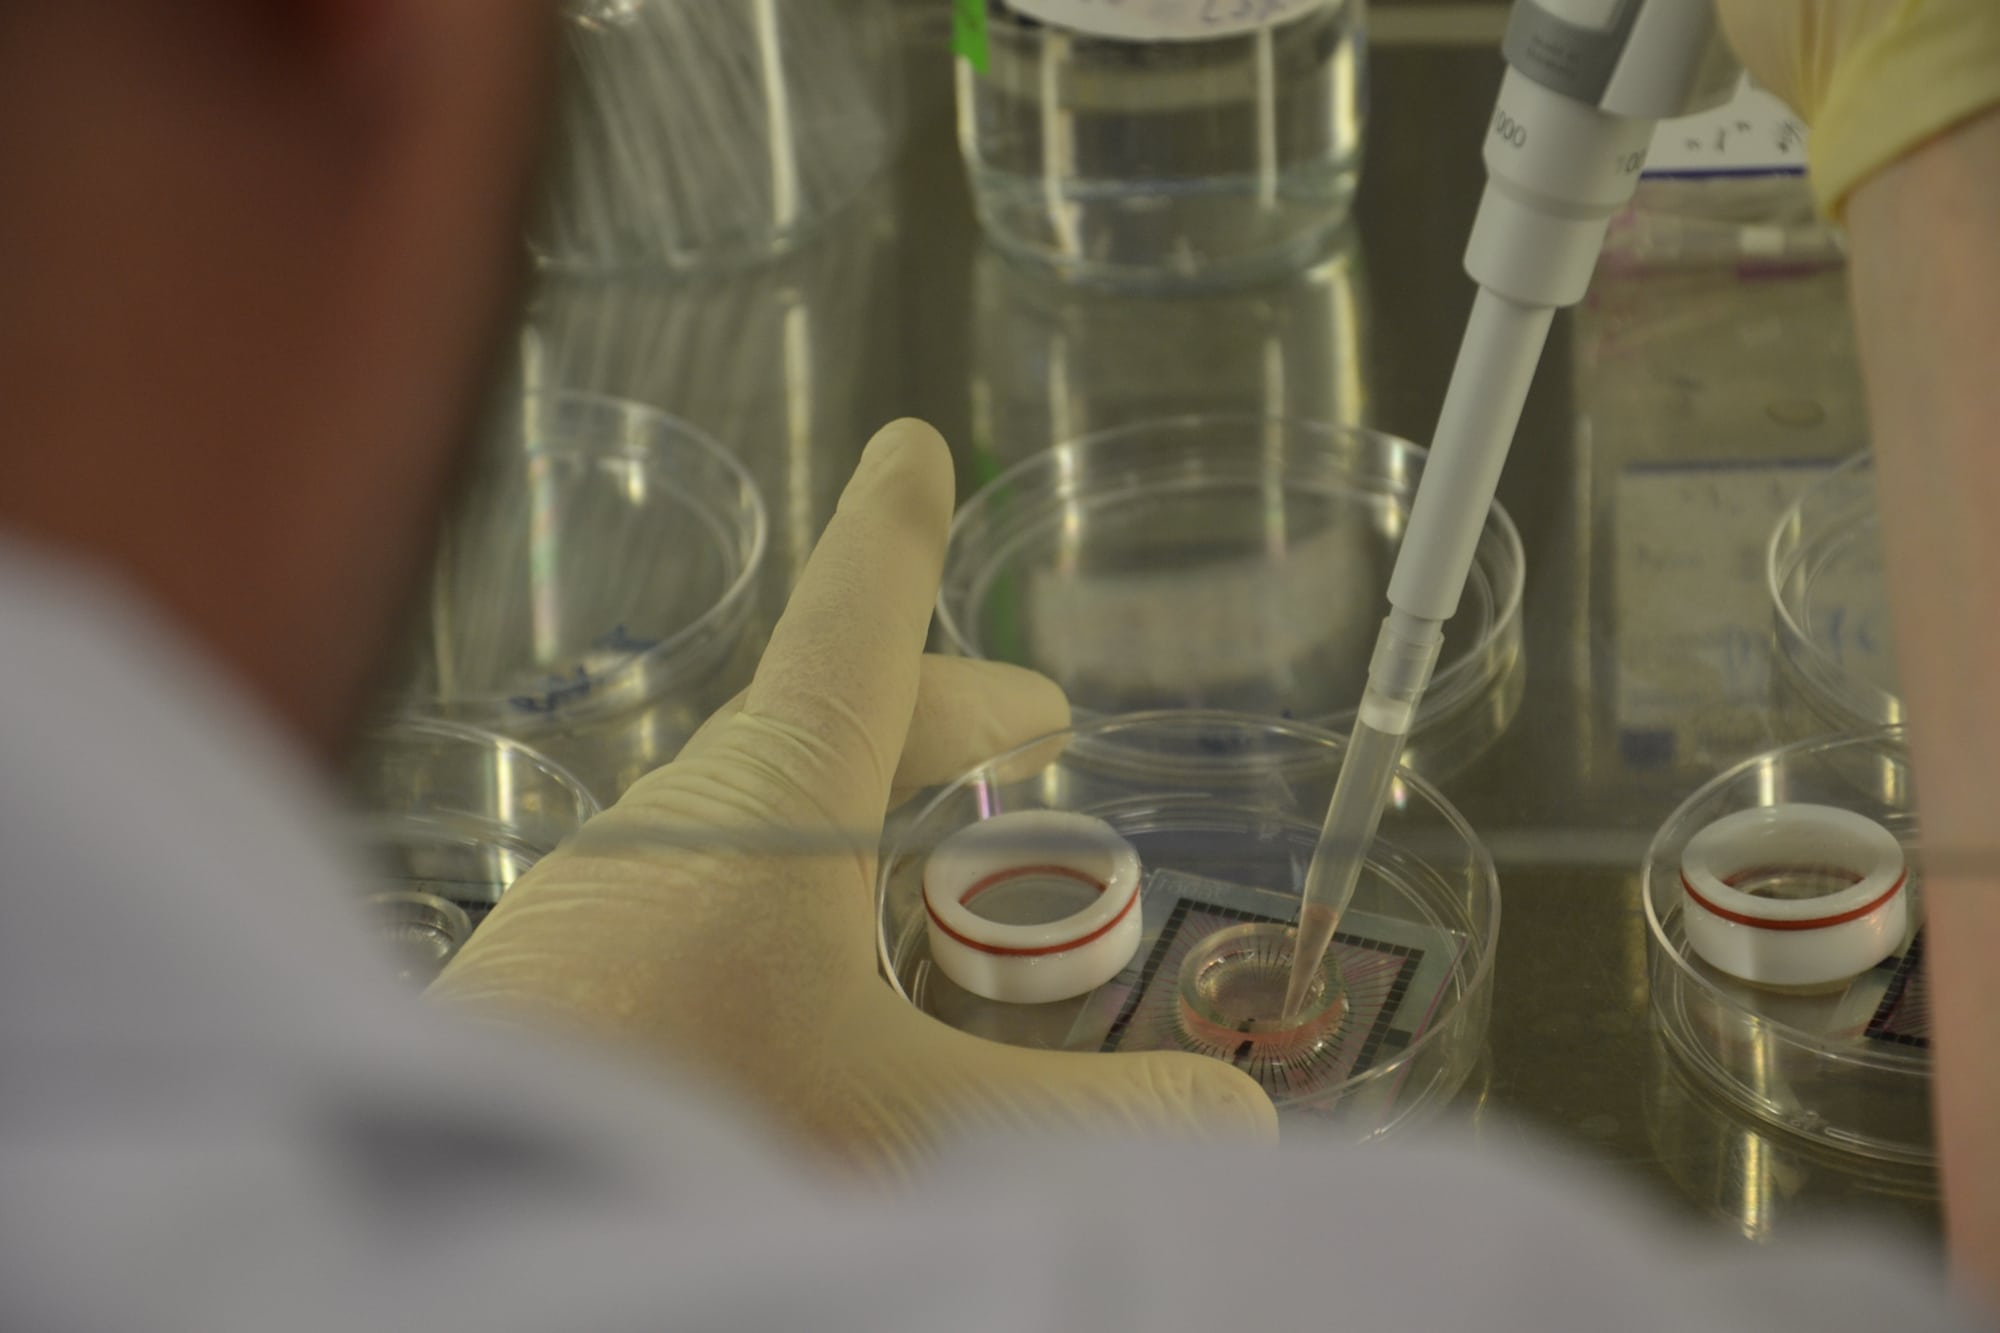

Cellf
Technosphärenklänge #3
Guy Ben-Ary

cellF, 2015, Guy Ben-Ary in collaboration with Nathan Thompson, Andrew Fitch, Darren Moore, Stuart Hodgetts, Mike Edel and Douglas Bakkum
Guy Ben-Ary is an artist and a researcher at SymbioticA (University of Western Australia, Perth) an artistic laboratory dedicated to the research, learning and hands-on engagement with the life sciences. Recognised internationally as a major artist and innovator working across science and media arts, Guy specialises in biotechnological artwork, which aims to enrich our understanding of what it means to be alive. Guy’s work focuses on tissue engineering, microscopy and biological imaging. His research explores a number of fundamental themes that underpin the intersection of art and science; namely life and death, cybernetics, and artificial life. Much of Ben-Ary’s work is inspired by science and nature. His artworks utilise motion and growth and biological data to investigate technological aspects of today’s culture and the re-use of biological materials and technologies.
CellF is a multidisciplinary artwork than Guy Ben-Ary developed in collaboration with Nathan Thompson, Andrew Fitch, Darren Moore, Stuart Hodgetts, Mike Edel and Douglas Bakkum. It first premiered in Perth in 2015. In the work neurons living in a Petri dish perform duets with human musicians: Guy Ben-Ary had skin cells extracted and transformed, first into pluripotent stem cells, and then into neurons. These were grown into a culture of 100,000 living neurons. Lined with electrodes, these neurons form output via an analog synthesizer, cellF, allowing them to “jam” with human musicians.
CellF, a neural synthesizer, performed with Schneider TM (12 May) and Stine Janvin (13 May) as part of Technosphärenklänge #3 at HKW
12 – 13 May, 2017
The third edition of the Technosphärenklänge series, produced by the HKW in collaboration with CTM Festival, will present musical projects operating at the border of art and science. Three projects – the world’s first neural synthesizer that performs with human musicians; water droplets levitated and shaped by sound waves; and the interconnection of spatial sound and high-energy lasers – make current notions of materiality tangible and fundamentally re-think the relationship between nature, technology and human consciousness. All three projects require intensive research and constant collaboration between the artists, natural scientists and technologists. The following day, lectures and talks hosted together with Art Laboratory Berlin will explain the research and science behind the performances, and discuss the works’ social implications.
hp
Haus der Kulturen der Welt (HKW)
John-Foster-Dulles-Allee 10, 10557 Berlin
12 May 2017 – CONCERTS
19:00 CELLF in performance with Schneider TM
Link to recording on Soundcloud
20:00 FORCE FIELD by Evelina Domnitch & Dmitry Gelfand
21:00 LUMIÈRE III by Robert Henke
13 May 2017 – TALKS & CONCERTS
15:00 – 18:00 LECTURES & DISCUSSION with Guy Ben-Ary. Nathan Thompson, Evelina Domnitch & Dmitry Gelfand, Robert Henke. Moderated by Christian de Lutz (Art Laboratory Berlin)
Panel with Guy Ben-Ary, Nathan Thompson and Schneider TM on SoundCloud
18:00 CELLF in performance with Stíne Janvin
Link to recording:
http://guybenary.com/work/cellf/